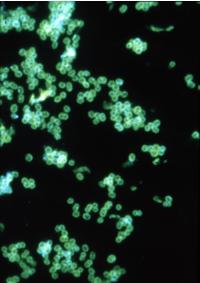
白濁

症狀體徵
白濁(gonorrhoea,膏淋,勞淋,淋病)是淋病雙球菌(gonococcus)引起的各種感染,但最常見的是泌尿生殖系統的化膿性感染,也可導致盆腔臟器及遠隔部位的感染。腎臟內科。1.單純型淋病即無合併症的淋病患者。
(1)男性淋病:
①急性淋菌性尿道炎:
A.潛伏期:一般為2~10天,平均2~5天。
B.臨床經過:開始尿道口灼癢、紅腫及外翻。排尿時灼痛,伴尿頻,尿道口有少量黏液性分泌物。3~4天后,尿道黏膜上皮發生多數局灶性壞死,產生大量膿性分泌物,排尿時刺痛,龜頭及包皮紅腫顯著。尿道中可見淋絲或血液,晨起時尿道口可結膿痂。淋球菌還侵入尿道腺體,使腺管閉塞,引起瀦留,易引起反覆再發。上述症狀持續1~2周,炎症逐漸減輕,但腺體內仍可潛藏一些淋球菌,故仍可分泌少量稀薄的漿液或膿性分泌物,晨起尿道口有黏著,稱為“餬口”現象,尿中仍可見有淋絲。如無併發症,經過合理治療,4~6周后,新生黏膜形成而痊癒。
C.全身症狀:伴輕重不等的全身症狀,如發熱、食欲不振、不適、頭痛等。病人易興奮、失眠,陰莖常發生異常勃起,並感刺痛,飲酒及性興奮過度可使症狀加劇。
D.轉歸:急性前尿道淋病如不經合理治療,或因劇烈運動、飲酒、性交、勃起及身體虛弱等因素,炎症向後尿道擴延,引起急性淋菌性後尿道炎,原已緩解的炎症又復增劇,尿急、尿痛、排尿困難,尿頻而尿量少,於排尿終了時常流出鮮血數滴。嚴重者可有尿瀦留,甚至尿閉。經6~8周后,急性炎症逐漸自行緩解。多數尿道腺和隱窩極易使淋球菌潛伏,如治療不當或未經治療,病程即轉為慢性。
②慢性淋菌性尿道炎:
病灶主要存在於尿道旁腺及各種腺體的隱窩中,其表現頗不一致。一般多無明顯症狀,當機體抵抗力減低,如過度疲勞、飲酒、性交時,即又出現尿道炎症狀,但較急性期炎症輕,尿道分泌物少而稀薄,僅於晨間在尿道口有膿痂黏附,即“餬口”現象,或以手指壓迫尿道深處,方可見有少量稀薄膿液流出。排尿時有輕微的尿道灼熱、刺痛、瘙癢、不適或尿道緊迫感。會陰部及前列腺處有壓痛。由於尿道長期存在炎症,尿道壁纖維組織增生而形成瘢痕,前尿道形成多處瘢痕時,使分泌物不能通暢排出,炎症易向後尿道、前列腺及精囊擴延,並發前列腺炎、精囊炎,甚至逆行向附睪蔓延,引起附睪炎。排尿終了時尿道中常混有來自後尿道的淋菌,因此,後尿道炎和前列腺炎又為前尿道炎的傳染源。由於前列腺和精囊的分泌物排人後尿道,並不斷刺激後尿道,使其不斷增厚,反過來又影響腺管引流不暢。這樣相互影響,促使淋病病程遷延,不易治癒,並成為重要的傳染源。
(2)女性淋病:
①急性淋菌性尿道炎和宮頸炎:
潛伏期:女性尿道較短,故尿道炎較男性為輕。感染後開始症狀輕微或無症狀,一般經2~3天的潛伏期後,外陰部首先發炎,自覺瘙癢,行走時疼痛,相繼出現尿道炎、宮頸炎、尿道旁腺炎、前庭大腺炎及直腸炎等,其中以宮頸炎最常見。
淋菌性尿道炎及尿道旁腺炎:70%的女性淋病患者存在尿道感染。尿道口紅腫、有壓痛,以手指從陰道前壁壓迫尿道時,可從尿道及尿道旁腺開口處流出膿性分泌物,伴尿頻、尿急、尿痛。尿道旁腺極易同時受侵,急性期可形成膿腫,有波動,可有膿液流出,如不治療,數月後可形成蠶豆大小硬結,壓痛明顯,穿刺可有膿液抽出。尿道旁腺常為淋球菌潛藏的所在。淋菌性宮頸炎:常見,多與尿道炎同時出現。主要表現為多量膿性分泌物,即白帶。可見宮頸口充血,有膿性分泌物溢出,或為膿性黏稠分泌物將其堵塞。急性期如治療不徹底,易轉為慢性宮頸炎,並可上行感染。10%~17%的病人可發生盆腔炎、宮體炎、急性輸卵管炎、輸卵管卵巢膿腫及盆腔腹膜炎等。其症狀與一般急性盆腔炎相同。
②慢性淋菌性尿道炎和宮頸炎:急性淋病如未充分治療可轉為慢性。表現為下腹墜脹、腰酸背痛、白帶較多等。女性慢性淋病臨床症狀雖然輕微或不顯著,但由於淋球菌可長期潛藏於尿道旁腺、前庭大腺或子宮頸腺深處,以後常反覆發作,並為重要傳染源。另外,分泌物不斷刺激使黏膜發生浸漬,易誘發尖銳濕疣。
③妊娠期淋病:多無臨床症狀。患淋病的孕婦分娩時,可經過產道而感染胎兒,特別是胎位呈臀先露時尤易被感染,引起淋菌性外陰炎、陰道炎、尿道炎或尿道旁腺炎;可發生胎膜早破、羊膜腔感染、早產、產後敗血症和子宮內膜炎等;也可致胎兒發育遲緩、低體重新生兒和新生兒敗血症等。
④幼女淋菌性外陰陰道炎:外陰、會陰和肛周紅腫,陰道膿性分泌物較多,可引起尿痛、局部刺激症狀和潰爛。
2.有合併症型淋病即伴泌尿生殖系合併症的淋病患者。
(1)男性淋病的合併症:
①淋菌性前列腺炎和精囊腺炎:如精囊受累,精液中可混有血液。並發前列腺炎時,會陰部疼痛,直腸指診前列腺腫大、疼痛,精囊腺腫大。
②淋菌性附睪炎與尿道球腺炎:附睪疼痛、腫大及觸痛。並發尿道球腺炎時,會陰部可觸及腫大腺體,患者感不適或鈍痛。並發急性附睪炎時,陰囊紅腫、疼痛,附睪腫痛,精索增粗。
③淋菌性包皮龜頭炎:膿性分泌物的刺激可引起龜頭和包皮炎症。
④腺性尿道炎、瀦留囊腫、淋巴管炎、淋巴結炎及包皮腺膿腫:前尿道的隱窩及腺體可受侵犯,稱為腺性尿道炎。這些腺體如被堵塞,可形成瀦留囊腫,囊腫破裂後可形成尿道周圍囊腫。尿道旁腺或尿道周圍炎症可向陰莖海綿體擴延,常並發淋巴管炎、單側或雙側腹股溝淋巴結炎。陰莖系帶兩側的包皮腺也可被累及而形成膿腫。
(2)女性淋病及其合併症:
①淋菌性前庭大腺炎:前庭大腺開口處紅腫、向外突出,有明顯壓痛及膿性分泌物,嚴重者腺管口被膿性分泌物堵塞而不能排泄,形成前庭大腺膿腫,有明顯疼痛,行動時感困難,可伴發熱、全身不適等症狀。
②淋菌性尿道旁腺炎:擠壓尿道旁腺處有膿性分泌物從尿道外口流出。
③淋菌性肛周炎:陰道分泌物較多時可引流至肛周和會陰引起炎症。
④淋菌性盆腔炎性疾病(gonococcalpelvicinflammatorydisease,GPID):包括急性輸卵管炎、子宮內膜炎、繼發性輸卵管卵巢膿腫、盆腔腹膜炎和盆腔膿腫等。10%~15%的淋菌性子宮內膜炎可上行感染,發生淋菌性盆腔炎、輸卵管炎、卵巢炎、附屬檔案炎及宮體炎。可引起輸卵管阻塞、積水及不孕。如與卵巢粘連,可導致輸卵管卵巢膿腫,一旦膿腫破裂可引起化膿性腹膜炎。66%~77%的盆腔炎多發生於月經後,主要見於年輕育齡婦女。典型症狀為雙側下腹劇痛,一側較重,發熱、全身不適,發熱前可有寒戰,常伴食欲不振、噁心和嘔吐。患者多有月經延長或不規則陰道出血,膿性白帶增多等。
3.泌尿生殖器外型淋病
(1)淋菌性眼炎:多見於新生兒和成人,結膜充血、水腫,有膿性分泌物,嚴重者可致角膜潰瘍和失明。新生兒在分娩通過產道時引起淋病性結膜炎,在出生後1~14天發生,表現為雙眼瞼明顯紅腫,有膿性分泌物溢出,如未及時治療,可累及角膜,形成角膜潰瘍和角膜白斑,導致失明。
(2)淋菌性咽炎:多無症狀,有症狀者可表現為咽喉部紅腫、水皰、膿皰和膿性分泌物。
(3)淋菌性直腸炎:兩性淋病患者直腸感染率是5%~50%,女性患者多於男性。10%患者有症狀,多為肛門瘙癢和燒灼感,排便疼痛,排出黏液和膿性分泌物,直腸充血、水腫、膿性分泌物、糜爛、小潰瘍及裂隙。女性直腸淋病的臨床表現與男性直腸淋病相同。
(4)淋菌性肝周炎(Fitz-Hugh/Curtis綜合徵):突發性右上腹疼痛,伴發熱、噁心和嘔吐,右上腹明顯壓痛。
4.播散型淋病即播散性淋球菌感染(disseminatedgonococcalinfection,DGI)。占淋病患者的0.2%~1.9%。
(1)全身症狀:低中度發熱,體溫多在39℃以下,可伴乏力、食慾下降等其他症狀。
(2)淋菌性皮炎:初起為直徑2~5mm圓形紅斑、斑丘疹或水皰,很快變成膿皰,周圍有紅暈,中央出血、壞死或結痂。偶見結節性紅斑、蕁麻疹或多形紅斑樣皮損。分布於軀幹、四肢、掌跖部,不發生於頭面部。4~5天消退,不遺留瘢痕。
(3)淋菌性關節炎、滑膜炎和腱鞘炎:多累及膝、踝、肘、腕和肩關節。2/3表現為遊走性不對稱性關節炎,約1/4表現為單關節痛。關節炎時關節紅、腫、積液或積膿,可引起骨質破壞和關節強直。常伴滑膜炎和腱鞘炎。
(4)淋菌性心內膜炎、腦膜炎和敗血症:心內膜炎主要累及主動脈瓣或二尖瓣。偶可累及腦膜、心內膜、骨骼、肝和乳腺。
5.淋病后綜合征(postgonorrheasyndrome,PGS)指淋病治療後實驗室檢查陰性而仍有某些症狀或體徵者。有尿道炎樣、前列腺炎樣症狀,如下腹墜痛、陰囊下墜、腰背酸痛、下肢無力、頭痛、頭暈、失眠、性慾減退和陽痿。慢性淋病可自行緩解,但易反覆再發,病人因患病日久,治療困難,失去治療信心,易引起神經衰弱,性交時快感消失或出現早泄。
疾病病因
病原體是淋病奈瑟菌(neisseriagonorrhoeae),也稱淋病雙球菌(gonococcus),簡稱淋球菌,屬奈瑟球菌科,奈瑟球菌屬。1.發現1879年,奈瑟從35例急性尿道炎、陰道炎及新生兒急性結膜炎病人的分泌物中,分離出淋病雙球菌。1885年,Bumm在人、牛或羊的凝固血清培養基上培養淋球菌獲得成功,將菌種接種於健康人的尿道內也可產生同樣的症狀。至此,淋球菌是淋病的病原體的結論始告成立。
2.形態與染色淋球菌呈卵圓形或豆形,菌體長0.6~0.8μm,寬約0.5μm。常成對排列,鄰近面扁平或稍凹陷,像兩粒豆子對在一起。無鞭毛,不形成芽孢。在急性感染的機體內,其形態較典型,多位於細胞漿內。慢性期則在細胞外。淋球菌革蘭染色陰性。用鹼性美藍染色時,菌體呈藍色。用PappehheimSaathof染色時,菌體呈紅色,背景為天藍色,十分清晰。淋球菌在人工培養基上有五種不同的菌落形態,分別稱為T1,T2,T3,T4,T5,其中T1和T2有毒力,T3和T4無菌毛,不能感染人類。
3.菌體結構淋球菌的致病主要與菌體外面的結構有密切關係。淋球菌外面結構為外膜,外膜的主要成分為膜蛋白、脂多糖和菌毛。膜蛋白可使淋球菌黏附於人體黏膜上,通過細胞吞噬作用進人細胞,在細胞內大量繁殖,導致細胞崩解,淋球菌擴散到黏膜下層引起感染。菌毛易黏附於子宮腔和口腔上皮細胞表面,有致病力及傳染性。
4.培養與生化特性在含有動物蛋白質如血液、血清、蛋黃、腹水等的培養基上生長良好。培養的適宜溫度為35~36℃,適宜pH為7.5,需要在5%二氧化碳的環境中培養。在人體尿道中可使葡萄糖發酵,但不能使果糖發酵,因此,可利用這一特性作葡萄糖發酵試驗,以與腦膜炎雙球菌鑑別。淋球菌不產生靛基質及硫化氫,在生長過程中可產生氧化酶,這在早期鑑定有一定意義。
5.營養分型根據淋球菌培養時所需要的胺基酸和核酸營養基礎,可將淋球菌分為35個營養型,其中Arg、Hyx、Ura型淋球菌可引起無症狀淋病及播散性淋病,對血清具有抗力,但對青黴素及其他一些藥物則敏感。
6.抵抗力淋球菌較為嬌嫩,最怕乾燥,適宜在潮濕、溫度為35~36℃、含2.5%~5.0%二氧化碳的條件下生長,其生長的最適pH為7.0~7.5。淋球菌對外界理化因素的抵抗力相當差,在完全乾燥的環境中1~2h即死亡,但若附著於衣褲和被褥中,則能生存18~24h,在厚層膿液或濕潤的物體上可存活數天。在50℃僅能存活5min。淋球菌對常用的黏膜殺菌劑抵抗力很弱。它對可溶性銀鹽尤其敏感,1∶4000硝酸銀溶液可使其在7min內死亡,使膿液中的淋球菌2min內死亡。1%苯酚(石炭酸)溶液能在3min內將其殺滅。除耐藥菌株外,淋球菌對抗生素敏感,但抗生素的最小抑菌濃度逐漸有所提高。
病理生理
1.發病機制 淋病雙球菌
淋病雙球菌(2)黏附:淋球菌菌毛上的特異性受體可與黏膜細胞相應部位結合;其外膜蛋白Ⅱ可介導黏附過程;它還可釋放IgAl分解酶,抗拒細胞的排斥作用。這樣,淋球菌與上皮細胞迅速黏和。微環境中的酸鹼度、離子橋、疏水結構和性激素等也可促進黏附過程。
(3)侵入與感染:淋球菌吸附於上皮細胞的微絨毛,其外膜蛋白I轉移至細胞膜內,然後淋球菌被細胞吞噬而進入細胞內。淋球菌菌毛可吸附於精子上,可迅速上行到宮頸管。宮頸管的黏液可暫時阻止淋球菌至宮腔,而在宮頸的柱狀上皮細胞內繁殖致病。淋球菌一旦侵入細胞,就開始增殖,並損傷上皮細胞。細胞溶解後釋放淋球菌至黏膜下間隙,引起黏膜下層的感染。
(4)病變形成:淋球菌侵人黏膜下層後繼續增殖,約在36h內繁殖一代。通過其內毒素脂多糖、補體和IgM等協同作用,形成炎症反應,使黏膜紅腫。同時,由於白細胞的聚集和死亡,上皮細胞的壞死與脫落,出現了膿液。腺體和隱窩開口處病變最為嚴重。
(5)蔓延播散:淋球菌感染後造成的炎症可沿泌尿、生殖道蔓延播散,在男性可擴展至前列腺、精囊腺、輸精管和附睪,在女性可蔓延到子宮、輸卵管和盆腔。嚴重時淋球菌可進入血液向全身各個組織器官播散,導致播散性感染。
2.耐藥機制
 淋病雙球菌
淋病雙球菌①PPNG菌株:為由細菌的質粒介導的耐青黴素菌株。近年來,已分離出不同質粒型的PPNG菌株。
②CMRNG菌株:是由細菌染色體介導的耐藥菌株。其耐藥譜廣泛,包括青黴素、四環素、頭孢菌素、鏈黴素和大觀黴素等。
③TRNG菌株:為由細菌質粒介導的耐四環素菌株。
④耐氟喹諾酮菌株:是由細菌染色體介導的耐藥菌株,耐藥譜包括環丙沙星、氟哌酸和氧氟沙星(氟嗪酸)等。
(2)耐藥菌株產生的原因:
①PPNG菌株:該菌株具有一種染色體外遺傳物質,稱質粒,系由嗜血菌屬獲得的控制酶所產生,並可遺傳給後代。質粒使胞質中攜帶耐藥性的基因R因子突變,從而帶有產生β-內醯胺酶的密碼。此酶可裂解青黴素的β-內醯胺環,使其失去抗菌作用。
②CMRNG菌株:淋球菌染色體中的許多遺傳位點都可發生基因突變,從而改變了藥物作用位點,導致耐藥性的產生。
③TRNG菌株:其耐藥原因的具體細節尚不清楚。
④耐氟喹諾酮菌株:涉及淋球菌染色體中數個遺傳位點的基因突變,不同位點的聯合突變決定耐藥的程度和方式。已報導有3種耐藥機制:gyrA基因編碼的DNA鏇轉酶A亞單位發生突變;parC基因編碼的DNA拓撲異構酶Ⅳ發生突變;細胞內藥物累積量減少。
(3)促使淋球菌耐藥的因素:
①抗生素劑量不足:使淋球菌長期處於亞治療劑量的作用下,日久便產生對青黴素類的耐藥性。
②濫用抗生素進行預防:已證明,隨意使用青黴素作化學預防很容易促進青黴素耐藥菌株的產生。
③抗生素多劑量治療:抗生素多劑量治療更易在體內選擇出氟喹諾酮類耐藥性增高的淋球菌菌株。
分型:當前,可將淋病分為以下若干型別。
1.單純型淋病
(1)男性淋病:
①急性淋菌性尿道炎。
②慢性淋菌性尿道炎。
(2)女性淋病:
①急性淋菌性尿道炎和宮頸炎。
②慢性淋菌性尿道炎和宮頸炎。
③妊娠期淋病。
④幼女淋菌性外陰陰道炎。
2.有合併症型淋病
(1)男性淋病的合併症:
①淋菌性前列腺炎和精囊腺炎。
②淋菌性附睪炎與尿道球腺炎。
③淋菌性包皮龜頭炎。
④腺性尿道炎、瀦留囊腫、淋巴管炎、淋巴結炎及包皮腺膿腫。
(2)女性淋病及其合併症:
①淋菌性前庭大腺炎。
②淋菌性尿道旁腺炎。
③淋菌性肛周炎。
④淋菌性盆腔炎性疾病。
3.泌尿生殖器外型淋病
(1)淋菌性眼炎。
(2)淋菌性咽炎。
(3)淋菌性直腸炎。
(4)淋菌性肝周炎。
4.播散型淋病
(1)淋菌性皮炎。
(2)淋菌性關節炎、滑膜炎和腱鞘炎。
(3)淋菌性心內膜炎、腦膜炎和敗血症。
5.淋病后綜合征。
病理生理
發病機制
⑴對上皮的親和力:淋球菌對柱狀上皮和移行上皮有特別的親和力。男女性尿道,女性宮頸覆蓋柱狀上皮和移行上皮,故易受淋球菌侵襲,而男性舟狀窩和女性陰道為復層扁平上皮覆蓋,對其抵抗力較強,一般不受侵犯,或炎症很輕,故成年婦女淋菌性陰道炎少見。幼女由於陰道黏膜為柱狀上皮,因此易於受染。皮膚不易被淋球菌感染,罕見有原發性淋球菌皮膚感染。人類對淋球菌無先天免疫性,痊癒後可發生再感染。
⑵黏附:淋球菌菌毛上的特異性受體可與黏膜細胞相應部位結合;其外膜蛋白Ⅱ可介導黏附過程;它還可釋放IgAl分解酶,抗拒細胞的排斥作用。這樣,淋球菌與上皮細胞迅速黏和。微環境中的酸鹼度、離子橋、疏水結構和性激素等也可促進黏附過程。
⑶侵入與感染:淋球菌吸附於上皮細胞的微絨毛,其外膜蛋白I轉移至細胞膜內,然後淋球菌被細胞吞噬而進入細胞內。淋球菌菌毛可吸附於精子上,可迅速上行到宮頸管。宮頸管的黏液可暫時阻止淋球菌至宮腔,而在宮頸的柱狀上皮細胞內繁殖致病。淋球菌一旦侵入細胞,就開始增殖,並損傷上皮細胞。細胞溶解後釋放淋球菌至黏膜下間隙,引起黏膜下層的感染。
⑷病變形成:淋球菌侵人黏膜下層後繼續增殖,約在36h內繁殖一代。通過其內毒素脂多糖、補體和IgM等協同作用,形成炎症反應,使黏膜紅腫。同時,由於白細胞的聚集和死亡,上皮細胞的壞死與脫落,出現了膿液。腺體和隱窩開口處病變最為嚴重。
⑸蔓延播散:淋球菌感染後造成的炎症可沿泌尿、生殖道蔓延播散,在男性可擴展至前列腺、精囊腺、輸精管和附睪,在女性可蔓延到子宮、輸卵管和盆腔。嚴重時淋球菌可進入血液向全身各個組織器官播散,導致播散性感染。
診斷檢查
診斷:淋病的診斷必須結合病史、體格檢查、實驗室檢查結果綜合分析才能作出。
實驗室檢查:
奈瑟氏淋病雙球菌
奈瑟氏淋病雙球菌不同部位的淋病可分別在相應部位取材。肛門內取材套用兩個棉拭,第一個棉拭常沾有糞便,應棄去,用另一棉拭重取。咽部淋病可由扁桃體、扁桃體隱窩或鼻咽腔取材。新生兒淋菌性結膜炎除由眼結膜取材外,還應從母體宮頸內取材。淋病性盆腔炎病人可從宮頸、直腸或尿道內取材,必要時也可在腹腔鏡直視下從輸卵管的膿性分泌物中取材。對淋病性皮炎可取皮損內容物。對以上部位的取材除作塗片檢查外,均應作淋菌培養。製作塗片時,應注意勿用力塗擦,以免損傷細胞使淋菌逸出。塗片勿過厚,以免染色時造成革蘭染色的假陽性。
2.培養檢查取分泌物、膿皰皰液、關節腔穿刺液或血液做淋球菌培養。主要用於進一步確診和需作藥物敏感試驗者,為確診淋病的主要方法。一般對女性淋病及男性臨床上符合診斷而塗片檢查為陰性者及播散性淋病,均需做培養。培養取材適當與否可影響檢查結果。在男性尿道內取材時應深入2~4cm處,在宮頸管內取材時應深入1~2cm處,徐徐轉動,並沾取少量黏膜。淋球菌對外界環境極為敏感,取材後立即接種,如需送到較遠距離的實驗室,應接種於運送培養基中。
所用培養基國外常用者有Thayer-Martin(TM)培養基、改良TM培養基及NewYorkcity(NYC)培養基。國內常用培養基為含有多黏菌素B(25U/m1)的血液瓊脂或朱古力瓊脂。淋球菌培養最適條件是在潮濕的含3%~10%二氧化碳、溫度35~370C的環境中。如無二氧化碳孵箱,可用36℃的燭缸(燃著的蠟燭在熄滅時,缸內的二氧化碳濃度為3%~5%)。24~48h觀察結果,菌落形態一般呈直徑0.5~1.0mm的圓形、凸起、濕潤、光滑、半透明或灰色,邊緣呈花瓣形。可根據培養淋球菌菌落的特徵和染色形態特點作初步鑑定。
培養如為陽性時可作藥敏試驗,包括紙片法或MIC測定及β-內醯胺酶試驗,以確定對某種抗生素的敏感性,合理選用藥物。
3.白細胞酯酶(LE)試驗是檢測中性粒細胞存在的簡單比色法。試紙中含吲哚羧酸酯,可被粒細胞酯酶水解成吲哚酚而呈現紫色。其敏感性和特異性,對有症狀的男性患者分別為76%~94%和53%~80%,而對無症狀的青少年男性病人則分別為72%與93%。該法簡便、快速、價廉,無需儀器設備和經培訓的技術人員,可作為大規模人群的初篩檢查。
4.生化試驗如需要與其他細菌鑑別,可根據需要取培養菌落作氧化酶試驗或糖發酵試驗。主要用於淋球菌的鑑定。
其他輔助檢查:
1.免疫學檢查
(1)直接螢光素標記抗體(DFA)檢查:以抗淋球菌蛋白I單克隆抗體作為免疫螢光試劑。該法快速、簡便,檢測女性標本優於Gram染色,但需螢光顯微鏡。
(2)固相免疫酶試驗(EIA):該法快速、簡便,易自動化操作,觀察結果客觀,不受標本運送及儲存的影響。塗片可用螢光素標記抗體染色,此法特異性及敏感均較高,但也有假陽性。近年來出現了一種增強發光酶免疫分析技術,方法靈敏、準確。
(3)協同凝集試驗:Phadebact單克隆抗體協同凝集試驗和SyvaMicrotrak螢光單克隆抗體試驗最常用,均有較好的敏感性與特異性,且快速、簡便,不需特殊儀器,可作為鑑定淋球菌的替代方法,適合常規套用。
2.分子生物學檢查
(1)核酸探針檢測法:目前最常用的試劑盒是PACE2系統。它採用與淋球菌rRNA互補、吖啶酯標記的單鏈DNA探針,與靶rRNA在液相雜交,以化學發光儀檢測。
(2)核酸擴增檢測法:
①聚合酶鏈反應(PCR):是一種體外擴增特異性DNA片段的技術,需要一對引物,可檢測到標本中一個基因拷貝,具有高度的敏感性。且快速、簡便,對檢測材料要求低。但PCR技術也存在假陽性、假陰性及引物不同結果不同等不少問題。
②連線酶鏈反應(LCR):是另一種體外核酸擴增技術,需要兩對引物,避免了PCR技術的缺點,敏感性和特異性均強,操作簡便,可檢測尿液標本。
鑑別診斷
1.與男、女性淋病鑑別的疾病(1)非特異性尿道炎:常有明顯的發病誘因,如插導尿管、尿道探子、泌尿生殖道或鄰近器官的炎症等病史。分泌物塗片染色可檢出Gram陽性球菌。
(2)NGU:臨床症狀與淋病類似,但較輕,潛伏期比淋病長,達1~3周,分泌物量少且呈漿液性,排尿困難極少見,無全身症狀,取分泌物作檢查時常可發現衣原體或支原體。
(3)軟下疳:損害一般位於外生殖器部位,發生於尿道口、舟狀窩者有膿性分泌物,尿道口紅腫和劇痛,潰瘍處可檢出Ducrey嗜血桿菌。
(4)生殖器皰疹:為HSV引起,損害為集簇性水皰,一般位於外生殖器、肛周,偶見於宮頸,發生於尿道者可有少量分泌物及尿道刺痛或不適,常伴局部燒灼感,疼痛明顯,可反覆發作。
(5)固定型藥疹:有服藥或注射用藥史,多由磺胺類、巴比妥類、水楊酸鹽類或四環素類等引起。常於外生殖器皮膚黏膜交界處發生紅斑、水腫、水皰、糜爛及滲出等,伴瘙癢或疼痛,尿道口無紅腫及外翻等。
(6)結核性尿道炎:可有尿道刺痛及少量分泌物,但無性接觸史,查不到淋球菌,可查見結核桿菌,伴有其他部位結核的症狀。
2.與男性淋病鑑別的疾病
(1)包皮龜頭炎:常見於包皮過長或包莖者,多由包皮垢刺激及繼發化膿菌感染所致,包皮內葉、龜頭及冠狀溝紅腫,有較多的污垢及膿性分泌物,無泌尿道症狀及尿道口紅腫、流膿等。
(2)尿混濁:尿液呈乳白色,靜置後有鹽類結晶的沉渣,不伴有自覺症狀。
3.與女性淋病鑑別的疾病
(1)念珠菌性陰道炎:外陰及陰道口瘙癢,白帶較多,如水樣或凝乳狀,陰道黏膜紅腫、糜爛,可有白膜附著於陰道壁,取白膜塗片鏡檢可見菌絲及孢子。
(2)滴蟲性陰道炎:自覺陰道內有蟻行樣瘙癢,陰道分泌物常呈粉紅色泡沫狀,陰道黏膜多有出血,宮頸可有草莓狀突起物和點狀出血,陰道分泌物中可檢出滴蟲。
(3)細菌性陰道病:主要為頑固性白帶增多,呈灰白色,非化膿性,並帶有“魚腥樣”氣味,從陰道分泌物中可檢出Gardner桿菌和厭氧菌。
(4)幼女金葡菌性外陰炎:多見於學齡前或學齡期女孩,好發於夏季,外陰、肛周紅腫,有膿皰或膿性分泌物、伴疼痛或瘙癢,分泌物塗片可檢出Gram陽性球菌。
4.與GPID鑑別的疾病有急性闌尾炎、感染性流產、盆腔子宮內膜異位症、異位妊娠、卵巢囊腫蒂扭轉或破裂等。
治療方案
1.治療原則對淋病,應遵循以下原則進行治療。(1)儘早確診,及時治療:首先,患病後應儘早確立診斷,在確診前不應隨意治療。其次,確診後應毫不遲疑地立即治療,切莫坐失良機。
(2)明確臨床類型:判斷是否為單純型,或有合併症型,或播散型。臨床分型對正確地指導治療極其重要。
(3)明確有無耐藥:明確是否耐青黴素,耐四環素等,這也有助於正確地指導治療。
(4)明確是否合併衣原體或支原體感染:若合併衣原體或支原體感染時,應擬訂聯合化療方案進行治療。
(5)正確、足量、規則、全面治療:應選擇對淋球菌最敏感的藥物進行治療,儘可能作藥敏試驗,過敏試驗或β-內醯胺酶測定。藥量要充足,療程要正規,用藥方法要正確。應選擇各種有效的方法全面治療。
(6)嚴格考核療效並追蹤觀察:應當嚴格掌握治癒標準,堅持療效考核。只有達到治癒標準後,才能判斷為痊癒,以防復發。治癒者應堅持定期複查,觀察足夠長的一段時期。
(7)同時檢查、治療其性伴侶:患者夫妻或性伴侶雙方應同時接受檢查和治療。
2.一般療法
(1)性隔離:禁止性生活。
(2)休息:伴有高熱,嚴重合併症的STD患者要適當休息,必要時應臥床休息。
(3)維持水,電解質,糖水化合物的必須與平衡,補充高糖,高蛋白飲食。
3.全身療法
(1)治淋藥物的評價和適應證:治療淋病的藥物很多,但應以高效、安全和價格適宜為原則進行選擇。
①青黴素類:通過破壞菌壁合成而起殺菌作用。此類藥物適於治療非耐青黴素酶的淋球菌(PPNG)引起的淋病,是本病的“標準療法”。然而,在治療前不作藥敏試驗,將其作為常規療法是不適當的,當PPNG菌株的流行率大於5%時,不應採用青黴素類治療,而應選用其他製劑。加服丙磺舒的目的是減慢青黴素自腎臟排出,並減少其與血漿蛋白結合,提高血內水平,延長半衰期,以充分發揮其抗菌作用。
 β-內醯胺酶抑制劑
β-內醯胺酶抑制劑③氨基糖甙類和氨基環狀糖醇類:主要作用為抑制菌體蛋白合成。用於治療對青黴素耐藥或過敏的患者。前一類常用者有慶大黴素(gentamycin)、卡那黴素(kanamycin)、阿米卡星(丁胺卡那黴素)和奈替米星(乙基西梭黴素);後一類藥物主要是大觀黴素(淋必治),它對PPNG菌株和非PPNG菌株引起的單純型淋病的治癒率高達98%以上,對有合併症型淋病也有極佳的療效;並且,該藥與青黴素和頭孢菌素類不產生交叉耐藥性,使用安全,是治療淋病的最佳藥物之一。目前,在一些地區已出現了耐大觀黴素的淋球菌菌株。其換代產品trospectomycin的抗菌譜較大觀黴素寬,包括Gram陽性菌、陰性菌、厭氧菌和衣原體,並且,它的組織內濃度更高,半衰期更長,因此對淋病效果更好,還對衣原體性尿道炎有較好的療效。
④頭孢菌素類:具有破壞菌壁和抑制菌體蛋白合成的作用。雖也屬於含β-內醯胺環的抗生素,但它們對β-內醯胺酶比較穩定或十分穩定,因此,對PPNG菌株和染色體介導的耐藥菌株所致的淋病,常能有效地取代青黴素類。大觀黴素耐藥菌株的出現使它們成為可行性代用品。常用的頭孢菌素有頭孢唑林(cefazolin)、頭孢西丁(cefoxitin)、頭孢呋辛(西力欣)、頭孢噻肟(cefotaxime)、頭孢哌酮(先鋒必)、頭孢唑肟(益保世靈)、頭孢他啶(復達欣)和頭孢曲松(頭孢三嗪)。其中以頭孢曲松(頭孢三嗪)和頭孢他啶療效較佳。拉氧頭孢(氧雜頭霉唑)在腦脊液中濃度很高,很適於治療淋菌性腦膜炎。
⑤氟喹諾酮類:通過抑制DNA鏇轉酶而抑制菌體DNA及蛋白合成。治療淋病常用的製劑有諾氟沙星(氟哌酸)、依諾沙星(氟啶酸)、氧氟沙星(氟嗪酸)和環丙沙星(環丙氟哌酸)等。在體外試驗中,它們對PPNG菌株和非PPNG菌株均有良好的抗菌作用。據報告,諾氟沙星(氟哌酸)對單純型淋病的治癒率為97%,依諾沙星(氟啶酸)、氧氟沙星(氟嗪酸)和環丙沙星(環丙氟哌酸)治療淋病的效果很好,對衣原體感染也有一定的療效。近年,又有一種新藥氟羅沙星(多氟哌酸)問世,它抗菌譜廣,血清半衰期長,每天口服1次即可。
⑥四環素類:通過抑制菌體蛋白的生物合成而發揮作用。對淋病也有較好的療效,但不作為一線用藥。常用的有四環素(tetracycline)、多西環素(強力黴素)和米諾環素(美滿黴素)等。
⑦大環內酯類:抑制菌體蛋白的生物合成。不作為一線用藥,主要用作四環素類的替代品。近來報告,阿奇黴素(azithromycin)單劑量1.0g對無合併症淋病的治癒率為96.4%,對同時合併衣原體感染的治癒率為100%。
⑧氯黴素類:抑制菌體蛋白的生物合成。常用甲碸黴素(將克)單劑量2.5g,對無合併症淋病的治癒率為93%。
⑨林可黴素類:在體內組織濃度高,低毒,安全,對厭氧菌有良效。常用克林黴素(氯潔黴素)治療盆腔炎。
⑩利福黴素類:對Gram陰性和陽性菌的作用均很強,且對麻風桿菌、病毒、衣原體感染有效。常用藥物有利福平(rifampin)和利福定(rifamdin)等。
○11磺胺類:對Gram陰性和陽性菌均有較強的抑制作用。常用的藥物有磺胺甲噁唑(新諾明)、磺胺甲噁唑/甲氧苄啶(複方新諾明)及丙磺舒等。
(2)單純型淋病的治療:
①敏感菌株致急性單純型淋病:
A.如當地無耐青黴素菌株流行,或分離的淋球菌對青黴素敏感,可用普魯卡因青黴素480萬~640萬U,每天分2次肌內注射;或阿莫西林(羥氨苄青黴素)3.0g,1次口服;或氨苄西林(氨苄青黴素)3.5g,1次口服;或青黴素G480萬U,靜脈滴注,每天1次,共3天。以上均在第一天同時口服丙磺舒1.0g;其後均用多西環素(強力黴素)或米諾環素(美滿黴素)0.1g,口服,每天2次,共7天。
B.對青黴素過敏者可用四環素0.5g,口服,每天4次,共7天,孕婦或8歲以下兒童禁用;或多西環素(強力黴素)或米諾環素(美滿黴素)0.1g,口服,每天2次,共7天,孕婦禁用;或紅黴素0.5g,口服,每天4次,共7天。
②耐藥菌株致急性單純型淋病:
A.大觀黴素2.0g,1次肌內注射,必要時可增至4.0g。
B.舒他西林2.25g,1次口服;或1.5g~3.0g,1次肌內注射。均同時口服丙磺舒1.0g。
C.對大觀黴素不敏感者可用頭孢西丁2.0g,1次肌內注射;或頭孢呋辛1.5g,1次肌內注射;或頭孢噻肟1.0g,1次肌內注射;或頭孢曲松(頭孢三嗪)0.25g,1次肌內注射。以上均同時口服丙磺舒1.0g。
D.對上述藥物不敏感或過敏者,可用諾氟沙星(氟哌酸)0.4g,口服,每天2次,連用2~3天;或依諾沙星(氟啶酸)或氧氟沙星(氟嗪酸)0.2g~0.4g,口服,每天2次,連用2~3天;或環丙沙星(環丙氟哌酸)0.5g,口服,每天2次,連用2~3天。以上藥物孕婦,兒童及肝、腎功能不良者慎用或禁用。
E.慶大黴素12萬~24萬U,分2次肌內注射;或卡那黴素1.0~1.5g,分2次肌內注射;或阿米卡星(丁胺卡那黴素)0.4~0.8g,分2次肌內注射。均連用2~3天。孕婦及兒童禁用。
以上藥物治療後,均用多西環素(強力黴素)或米諾環素(美滿黴素)0.1g,口服,每天2次,共7天。
③慢性單純型淋病:
A.普魯卡因青黴素480萬U,分兩次肌內注射,連用3天,並諾氟沙星(氟哌酸)0.2g,口服,每天4次,連用7天。
B.青黴素G800萬U,靜脈滴注,每天1次,並諾氟沙星(氟哌酸)0.2g,口服,每天4次,同時用磺胺甲噁唑(SMZ)1.0g,口服,每天2次,連用7天。
C.大觀黴素2.0g,肌內注射,每天2次,連用2~3天。
D.頭孢曲松(頭孢三嗪)或頭孢噻肟1.0g,肌內注射,每天1次,連用2~3天。同時口服丙磺舒1.0g。
E.依諾沙星(氟啶酸)0.2g,口服,每天3次,共7~10天;或氧氟沙星(氟嗪酸)0.2~0.4g,口服,每天2次,共7~10天;或環丙沙星(環丙氟哌酸)0.25g,口服,每天3次,共7~10天。
F.奈替米星(乙基西梭黴素)0.1g,肌內注射,每天2次,連用5~7天。
G.利福平0.6g,口服,每天1次,並卡那黴素0.5g,肌內注射,每天2次,
連用7天。以上藥物治療後,均用多西環素(強力黴素)或米諾環素(美滿黴素)0.1g,口服,每天2次,共10~14天。
④孕婦和新生兒淋病:
A.孕婦淋病:氨苄西林(氨苄青黴素)3.5g,口服;或阿莫西林(羥氨苄青黴素)3.0g,口服;或普魯卡因青黴素480萬U,肌內注射;或頭孢曲松(頭孢三嗪)0.25g,肌內注射;或頭孢噻肟1.0g,肌內注射。以上均同時口服丙磺舒1.0g。或大觀黴素4.0g,肌內注射。以上其後均用紅黴素0.5g,口服,每天4次,共7天。禁用四環素。
B.新生兒淋病:對足月新生兒,普魯卡因青黴素10萬U/kg,靜脈注射或肌內注射;對低體重新生兒,普魯卡因青黴素5萬U/kg,靜脈注射或肌內注射。其母若為耐藥菌株感染,新生兒也要相應改藥。
C.幼女淋菌性外陰陰道炎:青黴素G10萬U/(kg?d),肌內注射,同時口服丙磺舒25mg/kg;或大觀黴素40mg/kg,肌內注射。以上藥物均可同時口服己烯雌酚0.5mg~1.0mg,每天1次。
(3)有合併症型淋病的治療:
①輕症:
 氨苄西林
氨苄西林B.氨苄西林(氨苄青黴素)或阿莫西林(羥氨苄青黴素),或四環素0.5g,口服,每天4次,共14~21天;或米諾環素(美滿黴素)0.1g,口服,每天2次,共14~21天。
C.頭孢曲松(頭孢三嗪)0.25~0.5g,肌內注射,每天1次,連用10天;或頭孢噻肟1.0g,肌內注射,每天1次,連用10天;或大觀黴素2.0g,肌內注射,每天2次,連用10天;或氧氟沙星(氟嗪酸)0.2~0.4g,口服,每天2次,共7~10天;或環丙沙星(環丙氟哌酸)0.25g,口服,每天3次,共7~10天。其後用多西環素(強力黴素)或米諾環素(美滿黴素)0.1g,口服,每天2次,共14~21天。
②重症:指診斷不明;伴外科情況;疑有盆腔膿腫;孕婦;體溫超過38℃;門診治療48h失敗者。
A.青黴素G1000萬~2000萬U,靜脈滴注,每天1次;或頭孢西丁2.0g,靜脈注射,每天4次。好轉後改用氨苄西林(氨苄青黴素)0.5g,靜脈注射,每天4次,連用10天。
B.四環素0.5g,靜脈注射,每天4次。好轉後改為0.5g,口服,每天4次,連用10天。
以上其後均用多西環素(強力黴素)或米諾環素(美滿黴素)0.1g,口服,每天2次,共14~21天。
③極重症:指病情嚴重且反覆發作,有中毒症狀、盆腔膿腫及合併厭氧菌感染者。
可用頭孢西丁2.0g,靜脈注射,每天4次,連用14天;或青黴素G2000萬U,靜脈滴注,每天1次,連用14天。以上均同時用慶大黴素1.5~2.0mg/kg,靜脈滴注或肌內注射,每8小時1次;或克林黴素(氯潔黴素)0.6g,靜脈注射,每天4次;或甲硝唑(metronidazole)2.0g,靜脈注射,每天1次。以上均應在病情改善後至少再用48h,然後繼用克林黴素(強力黴素)或米諾環素(美滿黴素)0.1g,口服,每天2次,共10~14天。
(4)泌尿生殖器外淋病的治療:
①菌性眼炎:
A.新生兒淋菌性眼炎:若對青黴素敏感,水劑青黴素G10萬U/(kg?d),分4次靜脈滴注,連用7天。若為耐藥菌株感染,頭孢曲松(頭孢三嗪)25~50mg/(kg?d),靜脈滴注或靜脈注射,連用7天;或頭孢噻肟25mg/(kg?d),肌內注射或靜脈注射,連用7天;或大觀黴素40mg/(kg?d),肌內注射,每天1次,連用7天。
B.成人淋菌性眼炎:同慢性單純型淋病的治療。若為青黴素敏感菌株感染,可用水劑青黴素G1000萬U,靜脈滴注,每天1次,連用5天。如為耐藥菌株感染,可用頭孢曲松(頭孢三嗪)1.0g,肌內注射,每天1次,連用5天;或頭孢噻肟1.0g,肌內注射,每天2次,連用5天;或大觀黴素2.0g,肌內注射,每天1次,連用5天。
②淋菌性咽炎:頭孢曲松(頭孢三嗪)0.25g,肌內注射,每天1次,連用2~3天;或普魯卡因青黴素480萬U,肌內注射,每天1次,連用2~3天;或諾氟沙星(氟哌酸)0.8g,口服,每天1次,共2~3天;或氧氟沙星(氟嗪酸)0.2g,口服,每天2次,共2~3天;或磺胺甲噁唑/甲氧苄啶(複方新諾明)2片,口服,每天3次,共7天。氨苄西林(氨苄青黴素),阿莫西林(羥氨苄青黴素)和大觀黴素對本病無效。
③淋菌性直腸炎:頭孢曲松(頭孢三嗪)0.25g,肌內注射,每天1次,連用2~3天;或大觀黴素2.0g,肌內注射,每天1次,連用2~3天;或諾氟沙星(氟哌酸)0.8g,口服,每天1次,共2~3天;或氧氟沙星(氟嗪酸)0.2g,口服,每天2次,共2~3天;或環丙沙星(環丙氟哌酸)0.25g,口服,每天2次,共2~3天。氨苄西林(氨苄青黴素)、阿莫西林(羥氨苄青黴素)和四環素對本病療效差,一般不用。
(5)播散型淋病的治療:
①如為敏感菌株所致,用青黴素G2000萬U,靜脈滴注,每天1次,控制後改用氨苄西林(氨苄青黴素)或阿莫西林(羥氨苄青黴素)0.5g,口服,每天4次,共10天。
 拉氧頭孢
拉氧頭孢(6)PGS的治療:PGS指淋病治療後實驗室檢查陰性而仍有某些症狀或體徵者。應具體分析其原因,採取相應的處理措施。
①感染性原因:根據檢測出的病原體及其藥物敏感試驗的結果,選用敏感的抗細菌、衣原體、支原體、病毒、寄生蟲或酵母菌藥物。若系衣原體感染,應予四環素類治療;如系L型淋球菌殘存,應選用頭孢菌素、氟喹諾酮類或壯觀黴素類,同時套用增強機體免疫功能的藥物如胸腺素或γ-干擾素等作輔助治療;如系棒狀桿菌、大腸桿菌、專性厭氧菌、白念珠菌、病毒或毛滴蟲等,應選用有針對性的藥物進行治療。阿奇黴素對淋球菌、衣原體及支原體都有較好的療效,可謂一箭三雕。
②非感染性原因:必須在認真檢查、分析,並明確其病因的基礎上,區別不同的情況加以妥善處理。對機械、物理或化學性刺激所致者,只要停止刺激即可,無須特殊處理。對慢性無菌性前列腺炎或前列腺痛,給予非甾體抗炎藥,如非普拉宗、吲哚美辛(消炎痛)等可使75%的病人症狀改善;α-腎上腺受體阻滯藥如酚苄明等可使尿流改善,減少前列腺內尿液反流,改善前列腺痛。潑尼松10mg,每天3次,共1~2周,加平滑肌解痙劑黃酮哌酯(泌尿靈)也可減輕排尿不暢,下腹不適。對心理障礙者,耐心地進行心理諮詢,可使不少患者不用藥而愈。部分病人可酌情給予安慰劑或鎮靜劑。尿道狹窄者應請泌尿外科醫生處理。
(7)淋病合併其他STD的治療:淋病常合併其他STD,如梅毒和NGU。對合併有梅毒的患者,應先治梅毒,往往梅毒治癒後,淋病也隨之痊癒,若仍有淋病的症狀,再針對淋病治療。對合併NGU的病例,應先治淋病,後治NGU;也可以同時治療這兩種疾病,即聯合化療。若合併毛滴蟲,念珠菌或其他病原體感染時,則應在治療淋病的同時或其後,進行相應的處理。
4.局部療法局部療法僅作為抗菌療法輔助措施,起清潔、去除分泌物等作用。
(1)泌尿生殖器淋病:
①可用高錳酸鉀溶液,潔爾陰洗劑或潔膚淨洗劑清洗局部,並消毒、抑菌。
②也可用苦參30g,野菊花30g,銀花20g,黃柏20g,蛇床子20g,白礬15g,側柏葉15g,水煎外洗患處。
(2)淋菌性眼炎:套用等滲鹽水或眼科緩衝液沖洗患眼,清除分泌物,每2小時1次。沖洗後用0.5%紅黴素滴眼液或1%硝酸銀滴眼液點眼。
(3)淋菌性咽炎:可用朵貝爾液含漱或溶菌酶片口含。
5.手術療法
(1)淋菌性盆腔炎:淋菌性盆腔炎患者發生輸卵管卵巢膿腫,經48~72h積極治療無效或破裂者,應手術切除病變組織,清洗腹腔,放置引流,並儘量保留生育功能。
(2)慢性淋病:慢性淋病並發明顯的尿道狹窄者,可行尿道擴張術或尿道環狀切除術。
6.愈標準與療後觀察
 生殖器感染
生殖器感染①臨床症狀和體徵全部消失。
②尿液澄清透明。
③男性應在臨床症狀消失後2周,經前列腺按摩,並全程尿及分段尿沉渣取材,女性應在臨床症狀消失後1周從宮頸口或尿道口取材,分別作前列腺按摩液、尿沉渣或分泌物塗片和培養,每5~7天1次,連續2次淋球菌培養均陰性。值得注意的是,PCR是通過檢測淋球菌隱蔽質粒上的CppB基因存在而確定淋球菌有無的,部分患者治癒後,尿道在一段時間內尚存在有已殺死的含CppB基因無害性、無繁殖力的菌體及其碎片,儘管塗片和培養未檢出淋球菌,但PCR可擴增CppB基因,仍可得到陽性結果。因此,PCR檢測結果不能作為淋病治癒的指標。
(2)療後觀察:
①對青黴素類治療的病例,治療結束後3~7天仍持續有淋病表現者,要考慮可能為PPNG菌株感染。應選用針對耐藥菌株的藥物進行治療。
②經上述治療後,仍有淋病表現者,可能系對大觀黴素或頭孢曲松(頭孢三嗪)耐藥。應作藥物敏感試驗,改用敏感藥物。
③經過治療後,淋病又復發,則為再感染或重複感染,不一定是治療失敗。應對患者進行宣傳教育,並對其性伴侶進行檢查,診斷,必要時予以治療。
④性伴侶的處理:凡在1個月內和淋病患者有過性接觸者,均應進行預防性治療。如有淋病證據者,則應按淋病的治療方案接受治療。
併發症:並發前列腺炎、精囊炎,甚至逆行向附睪蔓延,引起附睪炎。10%~17%的病人可發生盆腔炎、宮體炎、急性輸卵管炎、輸卵管卵巢膿腫及盆腔腹膜炎等。並發前列腺炎時,會陰部疼痛,直腸指診前列腺腫大、疼痛,精囊腺腫大。
預後及預防
預後:淋病如早期及時進行合理規範的治療,一般預後良好,治癒率可達95%,若延誤治療時機或治療不合理,可使病程遷延,可並發各種合併症或發展為播散性淋病,導致不育、不孕、異位妊娠、盆腔炎、尿道狹窄或失明,嚴重者甚至可危及生命。預防
淋病的預防還應注意應禁止淋病病人與兒童,特別是女孩同床、共浴或公用浴盆、浴巾等。在患病率較高的地區,應對所有新生兒用硝酸銀溶液或其他有效的抗生素滴眼液點眼。
水質現象
簡介自來水中出現的白色沉澱,類似豆漿,實際為空氣和水形成的氣水混合物,多發生在水管停水後又恢復供水的這個時段。
原因
停水後,水管內的水被用完,空氣進入管道;恢復供水時,管內的空氣在高壓狀態下與水均勻混合,形成了氣和水的混合物。當水龍頭被打開,氣和水的混合物一起流出,此時壓強降低,混合在水中的空氣被釋放出來,形成細小的氣泡,無數氣泡組合在一起,外觀給人的感覺就象是豆漿。“白濁”只是空氣混合到水中,對人體沒有傷害。
處理方法
一般排水3-5分鐘,或者將水盛出來放置一段時間,水中的空氣被全部釋放後,水就會恢復澄清的狀態。
流行病學
淋病不像梅毒,遠古就流行於歐亞大陸。在西方,淋病最早發生於何時何地,現今無從查證。Gonorrhoea一詞為公元二世紀希臘著名醫學家Galon首先提出,意為溢精。
1.傳染源包括淋病患者和淋球菌攜帶者。
2.傳播途徑
(1)性接觸:包括以下幾個方面。
①正常性交方式:以正常性交方式導致的感染最為常見。據報告,在淋病患者中,男女1次性交的感染率為22%~35%。成年女性淋病絕大多數系由直接性交而感染的。
②異常性交方式:在同性戀人群或性心理、性行為變態者,還可通過“口淫”、“肛交”及舌-生殖器等異常性交方式傳染對方。
(2)間接接觸:傳染的機會較小。包括以下方面。
①一般性接觸:患者的帶菌分泌物可污染衣褲、被褥、床單、寢具、浴盆、毛巾、肛表、尿布、坐式便器、馬桶圈、便盆及手紙等物品,可經這些物品傳染他人。
②醫源性接觸:檢查病人用過的器械、為患者注射過的針頭等可被淋球菌污染,若消毒不嚴而再次使用時,可傳染他人。
(3)垂直傳播:包括宮內感染、產道感染和生後生活中感染。
3.高危人群
 耐青黴素
耐青黴素(2)人群易感性的差異:女性較男性易於遭受淋球菌感染。這可能是男性的含菌分泌物可長時間存在於陰道之故。
4.影響流行的疾病因素淋病還應注意不斷出現的耐藥菌株的影響。由於淋球菌遺傳和變異的特性,不斷出現耐藥菌株。這使淋病的治療難度不斷增加,患病率上升。
5.流行狀況20世紀90年代以後,隨著AIDS的廣泛傳播和旨在控制無症狀性淋球菌感染的項目獲得成功,淋病的發病率逐漸下降,1995年,美國報告的淋病不足40萬例。
1997年,中國內地報告的淋病年發病率為18.15/10萬,占STD的48.61%。耐藥性淋球菌菌株近年來也不斷增加,包括耐青黴素和耐環丙沙星的菌株。

